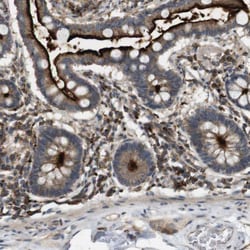
Invitrogen KSR1 Polyclonal Antibody 100 &mu;L; Unconjugated:Antibodies,

missing translation for 'onlineSavingsMsg'
Learn More
Learn More
Invitrogen™ KSR1 Polyclonal Antibody


Rabbit Polyclonal Antibody
Brand: Invitrogen™ PA5110765
This item is not returnable.
View return policy
Description
Immunogen sequence: SMIFGVKCKH CRLKCHNKCT KEAPACRISF LPLTRLRRTE SVPSDINNPV DRAAEPHFGT LPKALTKKEH PPAMNHLDSS SNPSSTTSST PSSPAPFPTS SNPSSATTPP NPSPGQRDSR FNFPA Highest antigen sequence indentity to the following orthologs: Rat - 95%, Mouse - 96%.
Part of a multiprotein signaling complex which promotes phosphorylation of Raf family members and activation of downstream MAP kinases. Independently of its kinase activity, acts as MAP2K1/MEK1 and MAP2K2/MEK2-dependent allosteric activator of BRAF; upon binding to MAP2K1/MEK1 or MAP2K2/MEK2, dimerizes with BRAF and promotes BRAF-mediated phosphorylation of MAP2K1/MEK1 and/or MAP2K2/MEK2 (PubMed:29433126). Promotes activation of MAPK1 and/or MAPK3, both in response to EGF and to cAMP. Its kinase activity is unsure. Some protein kinase activity has been detected in vitro, however the physiological relevance of this activity is unknown. [UniProt].
Specifications
| KSR1 | |
| Polyclonal | |
| Unconjugated | |
| KSR1 | |
| AW492498; B-KSR1; CAP kinase; D11Bhm183e; D11Bhm184e; hb; HB protein; kinase KSR1; Kinase suppressor of Ras 1; Ksr; KSR1; mKSR1; OTTHUMP00000162931; protein Hb; RSU2 | |
| Rabbit | |
| Antigen affinity chromatography | |
| RUO | |
| 8844 | |
| Store at 4°C short term. For long term storage, store at -20°C, avoiding freeze/thaw cycles. | |
| Liquid |
| Immunohistochemistry (Paraffin) | |
| 0.10 mg/mL | |
| PBS with 40% glycerol and 0.02% sodium azide; pH 7.2 | |
| Q8IVT5 | |
| KSR1 | |
| Recombinant Protein corresonding to Human KSR1. Recombinant protein control fragment (Product #RP-89822). | |
| 100 μL | |
| Primary | |
| Human | |
| Antibody | |
| IgG |
Product Content Correction
Your input is important to us. Please complete this form to provide feedback related to the content on this product.
Product Title
Spot an opportunity for improvement?Share a Content Correction